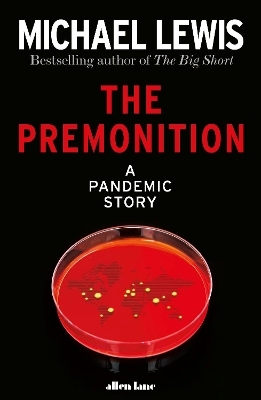
The Premonition - Michael Lewis

The Premonition
A Pandemic Story
Seiten
2021
Allen Lane (Verlag)
978-0-241-51247-0 (ISBN)
Allen Lane (Verlag)
978-0-241-51247-0 (ISBN)
- Titel ist leider vergriffen;
keine Neuauflage - Artikel merken
THE SUNDAY TIMES AND NEW YORK TIMES BESTSELLER
'Superb ... It is tremendous fun, tremendously told' Tom Whipple, The Times
'A fluid intellectual thriller' Daily Telegraph
From the global bestselling author of The Big Short, the gripping story of the maverick scientists who hunted down Covid-19
'It's a foreboding,' she said. 'A knowing that something is looming around the corner. Like how when the seasons change you can smell Fall in the air right before the leaves change and the wind turns cold.'
In January 2020, as people started dying from a new virus in Wuhan, China, few really understood the magnitude of what was happening. Except, that is, a small group of scientific misfits who in their different ways had been obsessed all their lives with how viruses spread and replicated - and with why the governments and the institutions that were supposed to look after us, kept making the same mistakes time and again.
This group saw what nobody else did. A pandemic was coming. We weren't prepared.
The Premonition is the extraordinary story of a group who anticipated, traced and hunted the coronavirus; who understood the need to think differently, to learn from history, to question everything; and to do all of this fast, in order to act, to save lives, communities, society itself. It's a story about the workings of the human mind; about the failures and triumphs of human judgement and imagination. It's the story of how we got to now.
'Lewis is a master of his form' Sunday Times
'Superb ... It is tremendous fun, tremendously told' Tom Whipple, The Times
'A fluid intellectual thriller' Daily Telegraph
From the global bestselling author of The Big Short, the gripping story of the maverick scientists who hunted down Covid-19
'It's a foreboding,' she said. 'A knowing that something is looming around the corner. Like how when the seasons change you can smell Fall in the air right before the leaves change and the wind turns cold.'
In January 2020, as people started dying from a new virus in Wuhan, China, few really understood the magnitude of what was happening. Except, that is, a small group of scientific misfits who in their different ways had been obsessed all their lives with how viruses spread and replicated - and with why the governments and the institutions that were supposed to look after us, kept making the same mistakes time and again.
This group saw what nobody else did. A pandemic was coming. We weren't prepared.
The Premonition is the extraordinary story of a group who anticipated, traced and hunted the coronavirus; who understood the need to think differently, to learn from history, to question everything; and to do all of this fast, in order to act, to save lives, communities, society itself. It's a story about the workings of the human mind; about the failures and triumphs of human judgement and imagination. It's the story of how we got to now.
'Lewis is a master of his form' Sunday Times
Michael Lewis's global bestselling books lift the lid on the biggest stories of our times. They include Flash Boys, a game-changing exposé of high-speed scamming; The Big Short, which was made into a hit Oscar-winning film; Liar's Poker, the book that defined the excesses of the 1980s; and, most recently, The Fifth Risk, revealing what happens when democracy unravels. Michael Lewis was born in New Orleans and educated at Princeton University and the London School of Economics.
| Erscheinungsdatum | 03.05.2021 |
|---|---|
| Verlagsort | London |
| Sprache | englisch |
| Maße | 162 x 240 mm |
| Gewicht | 536 g |
| Themenwelt | Sachbuch/Ratgeber ► Beruf / Finanzen / Recht / Wirtschaft ► Wirtschaft |
| Sozialwissenschaften ► Politik / Verwaltung ► Staat / Verwaltung | |
| Wirtschaft ► Volkswirtschaftslehre ► Makroökonomie | |
| Wirtschaft ► Volkswirtschaftslehre ► Wirtschaftspolitik | |
| ISBN-10 | 0-241-51247-6 / 0241512476 |
| ISBN-13 | 978-0-241-51247-0 / 9780241512470 |
| Zustand | Neuware |
| Informationen gemäß Produktsicherheitsverordnung (GPSR) | |
| Haben Sie eine Frage zum Produkt? |
Mehr entdecken
aus dem Bereich
aus dem Bereich
warum wir vor den Tech-Milliardären noch nicht einmal auf dem Mars …
Buch | Softcover (2025)
Suhrkamp (Verlag)
CHF 30,80
zum Stand der Dinge (des Alltags)
Buch | Softcover (2025)
Suhrkamp (Verlag)
CHF 30,80


